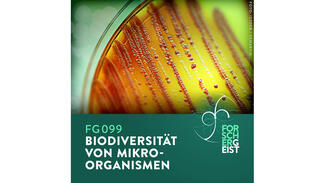
Forschergeist 099 (Cover) (Foto: iStock/Scharvik)

Dieser Audio-Podcast dreht sich um Lehren, Lernen und Forschen. Und er versucht dabei, den Kern dessen auszuloten, was Forschergeist ausmacht: Neugier, Ausdauer, Mut.

Forschergeist will Menschen zeigen, die neue oder ungewöhnliche Pfade erkunden. Wissenschaftler, die nie aufgegeben haben oder Umwege gehen mussten, um ihr Ziel zu erreichen. Querdenker, die unsere Gesellschaft mit ihren Ideen weiterbringen wollen. Andersmacher, die beharrlich gegen Ignoranz und Denkfaulheit ankämpfen. Es geht darum, wie sich das Bildungssystem weiterentwickeln muss, damit es von technologischen und gesellschaftlichen Entwicklungen nicht abgehängt wird. Hier kommen Menschen zu Wort, die Bildung offener und gerechter machen wollen. Nicht zuletzt steht die Frage im Mittelpunkt: Wir kann Wissenschaft und Forschung unser Leben bereichern?
Im Mittelpunkt des Podcasts stehen – wie der Titel schon andeutet – einzelne Forscher und deren Arbeit. Pro Sendung wird immer nur ein Forscher oder eine Forscherin vorgestellt. Forschergeist ist aber kein Interview-Format, in dem Standardfragen Punkt für Punkt abgearbeitet werden, denn das ist eher ungeeignet, um dafür zu werben, wie spannend Wissenschaft und Forschung sein können. Forschergeist zeigt, dass es sich lohnt, etwas tiefer über Forschungsfragen nachzudenken. Das Denken in plakativen Headlines oder verkürzten Zwei-Minuten-Beiträgen sei gerne anderen Medien überlassen. Die Gäste haben Zeit, über das zu sprechen, was sie bewegt, was sie antreibt, was ihren Forschergeist beflügelt. In der Regel sind die Episoden ca. 90 Minuten lang, manche können aber auch etwas länger oder kürzer sein. Jede Folge wird durchschnittlich rund 15.000 mal heruntergeladen.
Alle Forschergeist-Sendungen werden von Tim Pritlove moderiert und produziert. Er ist einer bekanntesten Podcaster Deutschlands und gestaltet unter dem Label Metaebene seit vielen Jahren Podcasts. Seine Produktionen beschäftigen sich mit Technologie-Themen ("CRE – Technik, Kultur, Gesellschaft" oder "Freakshow"), mit politischen Fragen ("Logbuch Netzpolitik" oder "Fokus Europa") oder mit Raumfahrt ("Raumzeit").
Wie funktioniert ein Podcast?
Ein Podcast ist eine Audio-Reihe im Internet. Hörer können die einzelnen Folgen herunterladen oder streamen und dann anhören, wann sie Zeit haben. Podcasts lassen sich auch abonnieren und beispielsweise in einer sogenannten Podcatcher-App auf dem Smartphone oder Tablet sammeln. Die App lädt neue Episoden nach Veröffentlichung automatisch herunter.
Empfehlungen der Redaktion
In der Forschergeist-Serie sind mittlerweile 91 Episoden erschienen.
Hanns Hatt
"Wir sollten im Leben öfter mal unserer Nase vertrauen", sagt der Biologe und Mediziner Hanns Hatt. Kein Wunder: Sein Gebiet ist die Geruchsforschung. Mit seinem Lehrstuhl für Zellphysiologie an der Ruhr-Uni in Bochum ist er auf diesem Gebiet weltweit ziemlich einzigartig. Und überaus erfolgreich. Seine Forschungen über das Riechen eröffnen völlig neue Horizonte, beispielsweise in der Medizin. Neue Erkenntnisse in der Erkennung von Prostata- oder Darmkrebs sind nicht zuletzt ihm zu verdanken. Und so lernen wir in dieser Folge wie das Riechen überhaupt funktioniert, was Düfte mit Lernen und Empfindungen zu tun haben, dass wir schon im Mutterleib riechen können und durch die Geruchswelt unserer Mutter geprägt werden, dass bestimmte Düfte die Menschen vertrauensvoller machen können, dass Düfte auch im Marketing wichtig sind, wie man mit den richtigen Düften auch junge Menschen zu Tausenden in den Kölner Dom locken kann und warum die Uni Bochum einen eigenen Duft namens "Knowledge" bekommen hat.
Lisa Rosa
Wir dürfen nicht auf dem Rücken unserer Kinder herumexperimentieren! Nur vordergründig signalisieren Sätze dieser Art verantwortliches Handeln im schulischen Alltag. Wenn man etwas genauer hinschaut – wie Lisa Rosa es tut – kann man solche Sätze schnell als Ausflüchte entlarven. Hinter denen man sich gut verstecken kann, wenn man nicht wirklich etwas verbessern will. Sätze wie diese sind der Grund dafür, dass sich Schule und Lernen seit vielen Jahrzehnten nicht entscheidend verändert haben. Diese Folge nimmt das Publikum mit auf eine Reise durch das Schulsystem und dessen Geschichte. Lisa Rosa war 20 Jahre lang selbst Lehrerin, an einer Gesamtschule in Berlin und an einem Gymnasium in Hamburg. Seit 2005 arbeitet sie in der Unterrichtsentwicklung am Landesinstitut für Lehrerbildung und Schulentwicklung Hamburg. Ein Gespräch über über optimale Lerngrößen, ein neues Lehrerbild, die Experimentierhaltung, die so oft fehlt, über belehrendes Lernen und über Projektlernen, über Open Education Resources und vor allem darüber, was es bedeutet, digitale Medien ins schulische Lernen und Lehren sinnvoll zu integrieren.
Franz Josef Radermacher
Eigentlich möchte doch jeder etwas für die Umwelt tun. Doch nicht nur, wenn die Lösung der Probleme von den sozial Schwachen bezahlt werden soll, stößt jede noch so gut gemeinte Initiative auf erbitterten Widerstand. Darüber hinaus führen viele Ansätze, mit denen die Weltgemeinschaft die Erderwärmung aufhalten will, am Ziel vorbei. Auch das Klima-Abkommen von Paris ist im Grunde schon heute zum Scheitern verurteilt. Wie also kann ein realistischer Ausweg aussehen, um dem Aufheizen der Erdatmosphäre Einhalt zu gebieten? Franz Josef Radermacher, Leiter des Forschungsinstituts für Anwendungsorientierte Wissensforschung (FAW) in Ulm, beschäftigt sich seit Jahrzehnten mit diesen Themen. In dieser Folge nennt er die tatsächlichen Verursacher des Klimawandels. Und entlarvt anhand von Zahlen, dass manche Annahmen zu den Dimensionen von Umweltbelastungen und zur Effektivität von Gegenmaßnahmen einfach nicht stimmen. Sollten sich die Chinesen am deutschen Klimaschutz ein Beispiel nehmen? Besser nicht.
Mark Benecke
Bei einem Mordfall kann jede Spur wichtig sein, mag sie auch auf den ersten Blick noch so abseitig erscheinen. Zum Beispiel was für Schmeißfliegen eine verweste Leiche besiedelt haben. Passen die Insekten eigentlich zum Fundort oder fand das Verbrechen ganz woanders statt? Solche Fragen sind nicht etwa der übersteigerten Phantasie von Drehbuchscheibern amerikanischer Krimiserien entsprungen, sondern ganz real. Und Mark Benecke hilft, sie zu beantworten. Als öffentlich bestellter und vereidigter Sachverständiger wird Benecke (geb. 1970) zu Rate gezogen, wenn es darum geht, die klassische Rechtsmedizin durch sein sehr spezielles Wissen zu ergänzen. Insekten und Mikroorganismen können nämlich einiges über die Umstände eines Tötungsdelikts verraten. So konnte Benecke etwa für ein aufsehenerregendes Gerichtsverfahren anhand von Fliegenmaden den Todeszeitpunkt zu bestimmen und dadurch das Alibi des Täters zu Fall zu bringen.
Aktuelle Episode
Neue Folgen erscheinen ungefähr alle vier Wochen.
Jörg Overmann
Der Kosmos der kleinsten Lebewesen auf dieser Welt ist noch weitgehend unbekanntes Terrain. Die Wissenschaft kennt derzeit rund 19.000 unterschiedliche Arten von Mikroorganismen, aber es gibt tatsächlich bis zu einer Milliarde. Dementsprechend vielfältig zeigen sich die Bakterien, die mikroskopisch kleinen Pilze und Algen – denn sie hatten vier Milliarden Jahre für ihre Evolution, also viel, viel länger als die Tiere und Pflanzen auf dieser Erde. Als Professor für Mikrobiologie an der TU Braunschweig und Wissenschaftlicher Direktor der Deutschen Sammlung von Mikroorganismen und Zellkulturen (DSMZ) erforscht Jörg Overmann dieses mit dem bloßen Auge nicht sichtbare Reich. Overmann wurde mit dem Wissenschaftspreis "Forschung in Verantwortung" 2022 ausgezeichnet, den der Stifterverband auf Vorschlag der Leibniz-Gemeinschaft vergibt.
Kontakt
Ansprechpartner für die redaktionelle Betreuung des Podcasts: